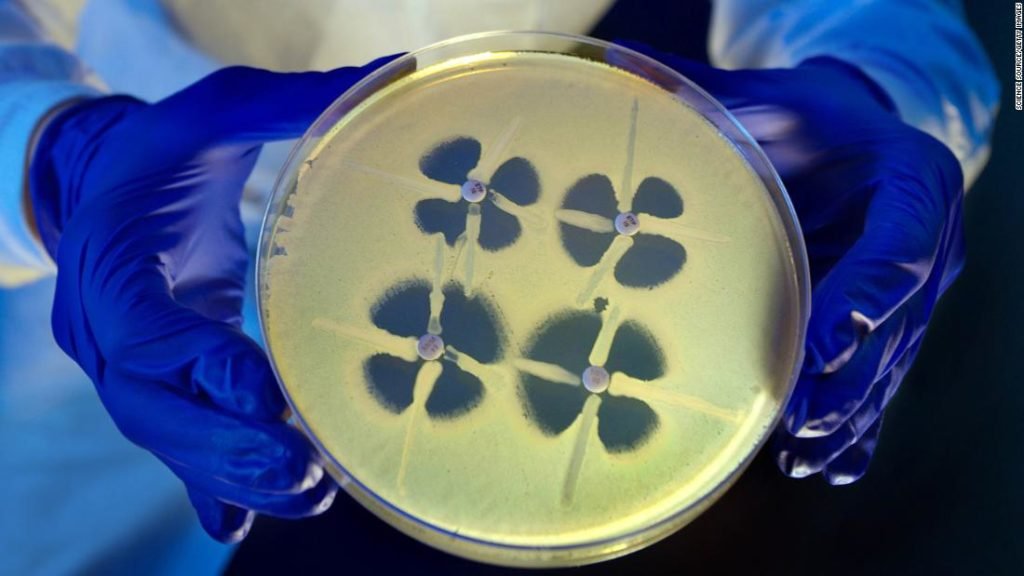

Surgeries in Mexico linked to antibiotic-resistant infections in US, CDC says
(CNN)Nearly a lots Americans who had surgical treatment in Tijuana, Mexico, have actually returned house with hazardous antibiotic-resistant infections, the United States Centers for Disease Control and Prevention stated Wednesday . “Infections triggered by this specific drug-resistant Pseudomonas are unusual in the United States and challenging to deal with,” the CDC stated. Clients usually need […]
